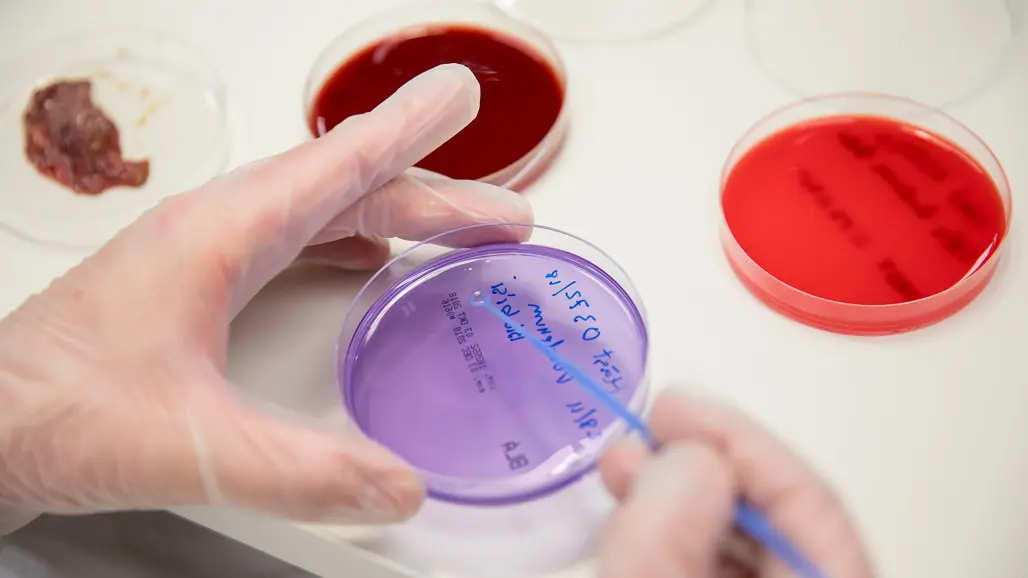

Antimicrobial resistance – the silent pandemic
The consumption of antibiotics in the world is increasing, and bacteria are becoming ever more resistant to this vital medical tool. Here we present two stories that exemplify how SLU contributes to this fight against antimicrobial resistance.
What would a future without effective antibiotics be like?
Imagine no longer being able to treat common infections such as pneumonia and having to slaughter a cow with a simple udder inflammation because there is no effective treatment. Or a pig farmer going bankrupt if his stock develops swine dysentery. All the infections that are treatable today suddenly become life-threatening.
According to the World Health Organisation (WHO), antibiotic resistance is one of the biggest threats to global health and food security, and the key message is that we need to work together to reduce the use of antibiotics and, at the same time, develop new drugs.
Bacteria have become increasingly resistant to antibiotics, a significant concern as resistant bacteria can spread in many different ways, directly between humans and animals or indirectly through food and the environment. The One Health approach is essential due to the strong links between people, animals and the environment.
In this article, we touch on two projects, which aim to reduce the use of antibiotics and contribute to the problem of resistance, one focusing on wastewater in Sweden. But we begin in East Africa and the antibiotic situation of poultry producers.
Poultry production in East Africa
We travelled to Kenya and Uganda to understand poultry production practices in these countries, where small-scale producers and bigger commercial farms are involved. Many farmers have a handful of free-range chickens for meat and/or egg production, which they sell or consume in their households. The commercial farms usually keep their birds indoors.



Difficult to access and costly
Poor roads make the farms inaccessible, making it difficult for veterinarians to access the farms. Usually, they make their visits by motorcycle. The cost of petrol to get a veterinarian to the farm can be significant, making the farmers unwilling to call in the experts.
Farmers who can afford to consult a veterinarian often wait until they have tried to treat the animal themselves, without success. By the time a veterinarian is contacted, it is often too late to cure the animal.
Digital knowledge platform in East Africa
SLU is contributing to a project that explores how information technology can be employed to reduce the use of antibiotics in East Africa.
A digital portal is being built to spread knowledge about common poultry diseases and their prevention, and information on the correct use of antibiotics.
The farmers will also be able to use the portal to register their use of pharmaceuticals and details about animal diseases. They will also have access to information on how to contact a veterinarian and where to find the nearest shop that supplies medicines. These shops must also register sales of drugs (reporting is already mandatory). Everyone who registers information will be able to see how their data compares with general trends in all the data entered.
Wastewater – a source of antibiotic resistance
In Sweden, Associate Professor Foon Yin Lai researches wastewater purification. Remnants of antimicrobial agents can spread to the groundwater, such as antimicrobial chemicals (e.g. antibiotics) and antibiotic resistance genes (ARGs). Foon Yin is studying how these agents can be eliminated and how to prevent the spread of antimicrobial resistance (AMR).
Many of the major sewage treatment plants help in removing some antimicrobial agents. However, for 13% of Swedish households, sewage treatment occurs at smaller plants, so-called on-site sewage facilities (OSSFs), closer to where it is used and discharged (via sewers).
Foon Yin has installed a device that has taken water samples over a year from an OSSF in a remote community in Småland in southern Sweden.
Foon Yin is looking forward to seeing the results of the analyses: how much are the antimicrobial chemicals and ARGs spreading? And how much does adding more treatment variables to the infiltration beds help to keep ARGs from spreading to the groundwater?

A One Health approach is essential for addressing antimicrobial resistance.
People, animals and our environment are closely interconnected, which is why a One Health approach is essential to tackling the threat of antimicrobial resistance. In this video, we explain the One Health approach.
SLU Future One Health is a platform that supports and promotes interdisciplinary research addressing issues such as antimicrobial resistance. You can read more about our work here.
More information about the two projects mentioned above:
- The SLU component of the MAD-tech-AMR project is led by Professor Susanna Sternberg Lewerin. You can read more about the project on JPIAMR:s webpage. (JPIAMR is a global collaborative organisation and platform to curb antimicrobial resistance (AMR) with a One Health approach).
- The STOP-ARG project is funded by FORMAS and led by Associate Professor Foon Yin Lai.
Story:
Eva-Stina Lindell, e-mail, Communications Officer, SLU Future One Health
Press & research contacts:
Susanna Sternberg Lewerin is a Professor at the Department of Animal Biosciences at SLU. E-mail.
Foon Yin Lai is an Associate Senior Lecturer at the Department of Aquatic Sciences and Assessment at SLU. E-mail.
Production:
SLU Division of Communication, e-mail
The content is free to share in its original form if the source/URL is cited.